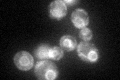
YNL149C
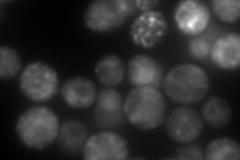
YNL149C

View description
Essential protein required for maturation of Gas1p and Pho8p; involved in protein trafficking; GFP-fusion protein localizes to the ER and YFP-fusion protein to the nuclear envelope-ER network; null mutants have a cell separation defect
Localization:
Intensity:
Fold change:
Significance:
-
C’ GFP library in SD
ER70.99 -
N' NOP1pr-GFP in SD

ER,punctate243.914 -
N' TEF2pr-mCherry in SD
ER,punctate228.9 -
N' NATIVEpr-GFP in SD

missing0 -
N' TEF2pr-VC and Cyto-VN in SD

below threshold23.4983 -
C’ GFP library in SD+DTT

ER67.640.95No -
C’ GFP library in SD+H2O2

ER48.120.67No -
C’ GFP library in Starvation Media

ER67.350.94No -
C’ GFP library on the background of Pup2-DaMP

N/A -
C’ GFP library on the background of CCT mutant

N/A0N/AYes
